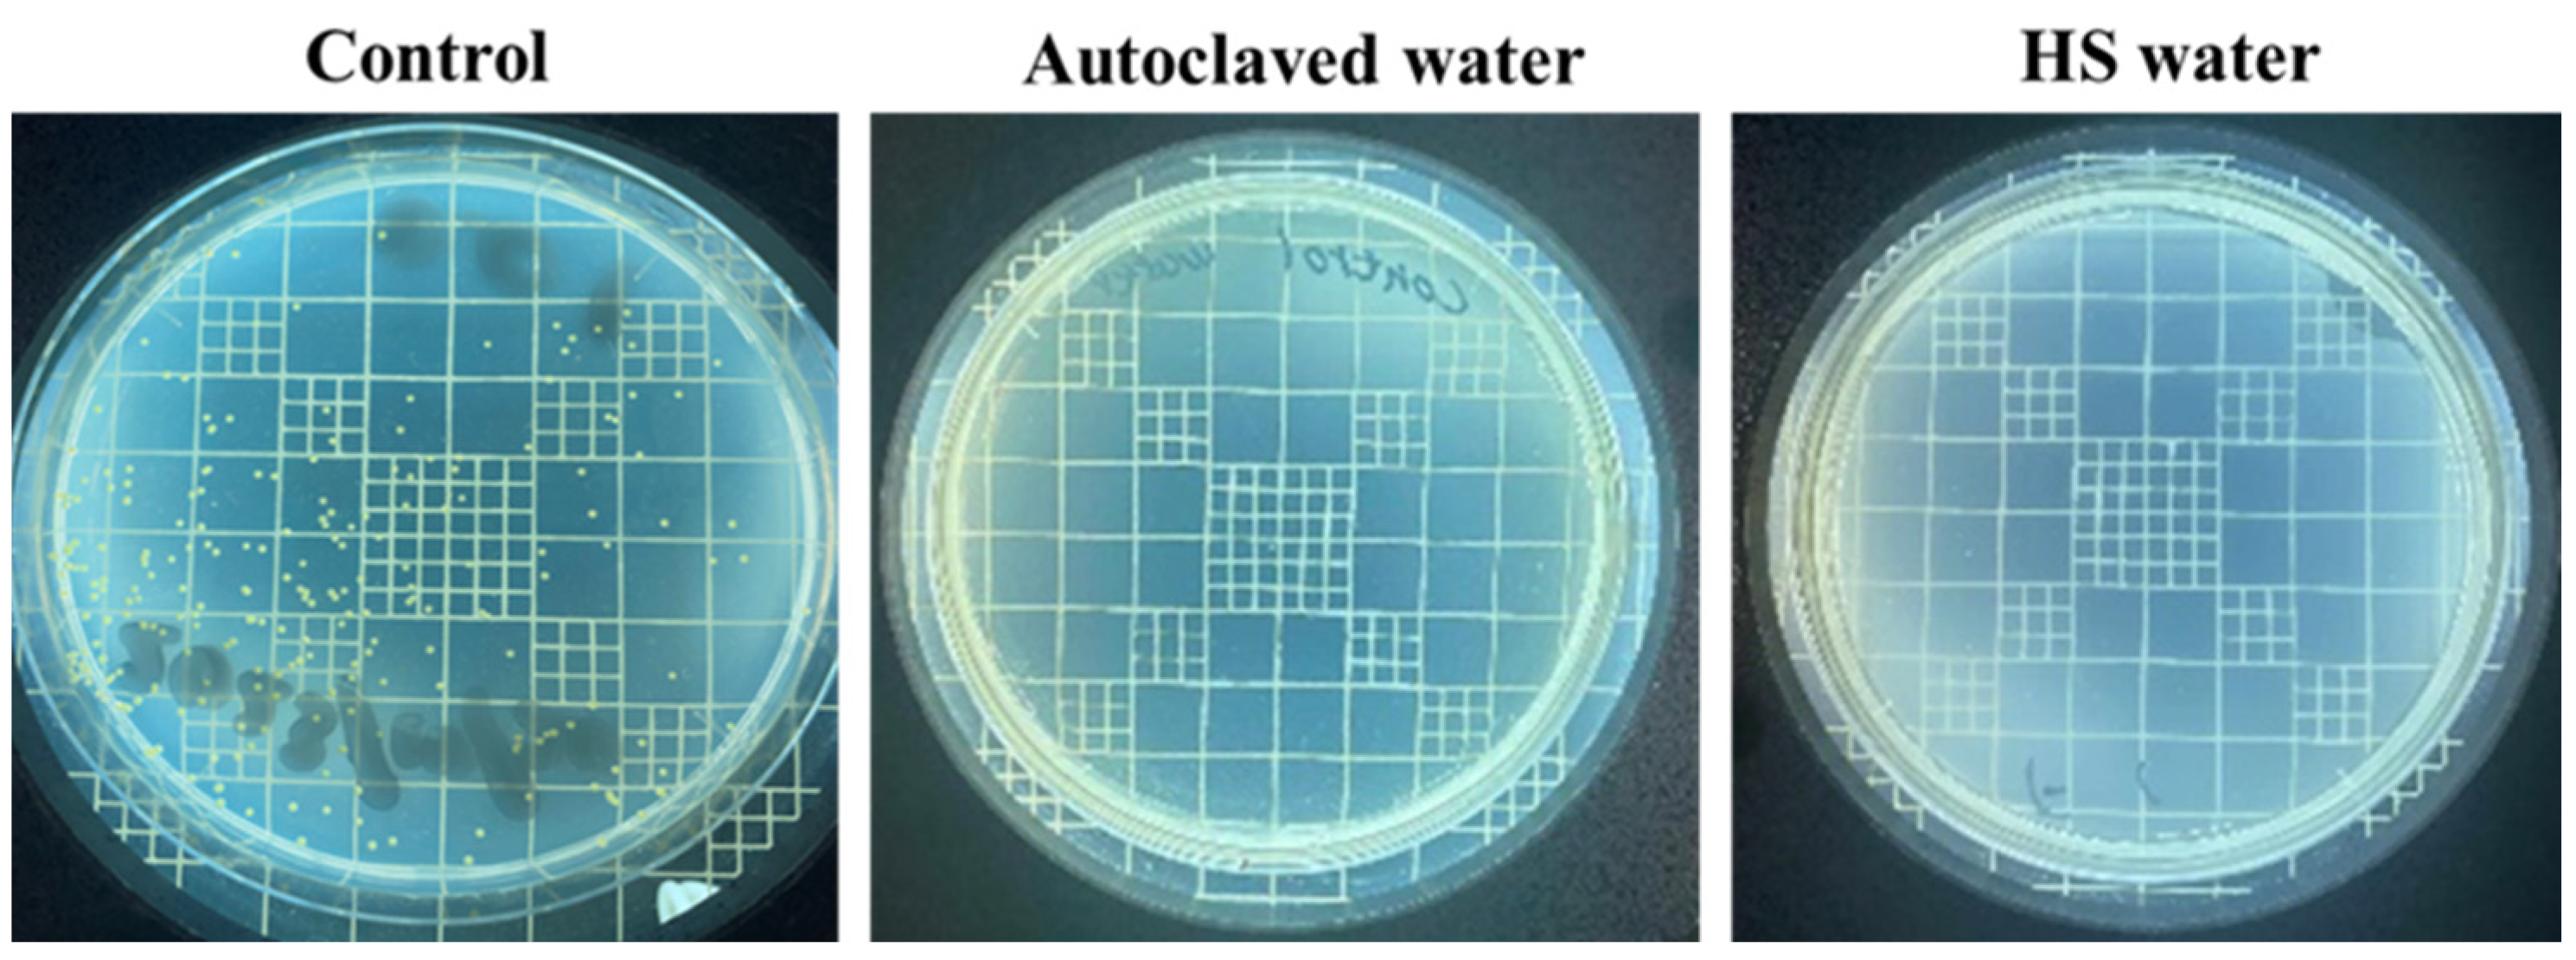
Polysaccharides 05 00008 g001

Utilization of Multi-Ionic Interaction of Yumoto Hot Springs for Enhancing the Moisturizing Properties of Hyaluronic Acid Sodium Salt
Abstract
1. Introduction
2. Materials and Methods
2.1. Materials
2.2. Characterization of HS Water
Investigating the Properties of HS Water
2.3. Characterization of HS Water Combined with HA
3. Results and Discussion
3.1. The Quality of Yumoto Onsen HS Water
3.2. Incorporation of HS Water in Combination with HA as a Moisturizing Agent
| Ions | Mw of HA * | Key Outcomes | Reference |
|---|---|---|---|
| Mg2+ and Cl− | High Mw | Non-invasive delivery of hyaluronan into the stratum corneum. | [17] |
| Na+, NH4+, Mg2+, Li+, SO42−, Cl−, SCN− | High and low Mw | Diffusion coefficients for solutions with sodium hyaluronate and salts inform modeling for pharmaceutical and engineering diffusion. | [34] |
| Ca2+ and Cl− | N.A | The binding of the calcium ions weakens the intramolecular hydrogen-bond network of hyaluronan, increasing the flexibility of the polymer chain. | [35] |
| Na+ and Cl− | Low Mw | Hyaluronic acid-coated aggregated vesicle formation. | [36] |
| HS water (Na+, Ca2+, Mg2+, SO42−, Cl−) | High Mw | Reduction in viscosity of HA solution in the presence of multi-ions in HS water; utility as an essential moisturizer. | This study |
4. Conclusions
Author Contributions
Funding
Institutional Review Board Statement
Data Availability Statement
Acknowledgments
Conflicts of Interest
References
- Des Marais, D.J.; Walter, M.R. Terrestrial Hot Spring Systems: Introduction. Astrobiology 2019, 19, 1419–1432. [Google Scholar] [CrossRef] [PubMed]
- Matz, H.; Orion, E.; Wolf, R. Balneotherapy in Dermatology. Dermatol. Ther. 2003, 16, 132–140. [Google Scholar] [CrossRef] [PubMed]
- Wang, H. A review of research papers on the health-promoting effects of hot springs reported in Japanese over the past 20 years. Jpn. Hot Spring Phys. Soc. 2006, 69, 81–102. [Google Scholar] [CrossRef]
- Koito Ryokan. Available online: https://koito-inn.co.jp/en/ (accessed on 10 April 2024).
- Biondi, N.; Martina, M.R.; Centini, M.; Anselmi, C.; Tredici, M.R. Hot Springs Cyanobacteria Endowed with Biological Activities for Cosmetic Applications: Evaluation of On-Site Collected Communities and Isolated Strains. Cosmetics 2023, 10, 81. [Google Scholar] [CrossRef]
- Kubota, K.; Machida, I.; Tamura, K.; Take, H.; Kurabayashi, H.; Akiba, T.; Tamura, J. Treatment of Refractory Cases of Atopic Dermatitis with Acidic Hot-Spring Bathing. Acta Derm. Venereol. 1997, 77, 452–454. [Google Scholar] [CrossRef] [PubMed]
- Chiarini, A.; Dal Pra, I.; Pacchiana, R.; Zumiani, G.; Zanoni, M.; Armato, U. Comano’s (Trentino) Thermal Water Interferes with Interleukin-6 Production and Secretion and with Cytokeratin-16 Expression by Cultured Human Psoriatic Keratinocytes: Further Potential Mechanisms of Its Anti-Psoriatic Action. Int. J. Mol. Med. 2006, 18, 1073–1079. [Google Scholar] [CrossRef] [PubMed][Green Version]
- Inaka, K.; Kimura, T. Comfortable and Dermatological Effects of Hot Spring Bathing Provide Demonstrative Insight into Improvement in the Rough Skin of Capybaras. Sci. Rep. 2021, 11, 23675. [Google Scholar] [CrossRef]
- Krutmann, J.; Bouloc, A.; Sore, G.; Bernard, B.A.; Passeron, T. The Skin Aging Exposome. J. Dermatol. Sci. 2017, 85, 152–161. [Google Scholar] [CrossRef] [PubMed]
- Vasvani, S.; Kulkarni, P.; Rawtani, D. Hyaluronic Acid: A Review on Its Biology, Aspects of Drug Delivery, Route of Administrations and a Special Emphasis on Its Approved Marketed Products and Recent Clinical Studies. Int. J. Biol. Macromol. 2020, 151, 1012–1029. [Google Scholar] [CrossRef]
- Becker, L.C.; Bergfeld, W.F.; Belsito, D.V.; Klaassen, C.D.; Marks, J.G.; Shank, R.C.; Slaga, T.J.; Snyder, P.W.; Cosmetic Ingredient Review Expert Panel; Andersen, F.A. Final Report of the Safety Assessment of Hyaluronic Acid, Potassium Hyaluronate, and Sodium Hyaluronate. Int. J. Toxicol. 2009, 28, 5–67. [Google Scholar] [CrossRef]
- Mourelle, M.L.; Gómez, C.P.; Legido, J.L. Hydrobiome of Thermal Waters: Potential Use in Dermocosmetics. Cosmetics 2023, 10, 94. [Google Scholar] [CrossRef]
- Al-Khateeb, R.; Prpic, J. Hyaluronic Acid: The Reason for Its Variety of Physiological and Biochemical Functional Properties. Appl. Clin. Res. Clin. Trials Regul. Aff. 2019, 6, 112–159. [Google Scholar] [CrossRef]
- Girish, K.S.; Kemparaju, K. The Magic Glue Hyaluronan and Its Eraser Hyaluronidase: A Biological Overview. Life Sci. 2007, 80, 1921–1943. [Google Scholar] [CrossRef] [PubMed]
- Taweechat, P.; Pandey, R.B.; Sompornpisut, P. Conformation, Flexibility and Hydration of Hyaluronic Acid by Molecular Dynamics Simulations. Carbohydr. Res. 2020, 493, 108026. [Google Scholar] [CrossRef] [PubMed]
- Svarca, A.; Grava, A.; Dubnika, A.; Ramata-Stunda, A.; Narnickis, R.; Aunina, K.; Rieksta, E.; Boroduskis, M.; Jurgelane, I.; Locs, J.; et al. Calcium Phosphate/Hyaluronic Acid Composite Hydrogels for Local Antiosteoporotic Drug Delivery. Front. Bioeng. Biotechnol. 2022, 10, 917765. [Google Scholar] [CrossRef] [PubMed]
- Fujii, M.Y.; Okishima, A.; Ichiwata, H.S.; Oka, T. Biocompatible Topical Delivery System of High-Molecular-Weight Hyaluronan into Human Stratum Corneum Using Magnesium Chloride. Sci. Rep. 2023, 13, 10782. [Google Scholar] [CrossRef] [PubMed]
- Jiang, Y.-H.; Lou, Y.-Y.; Li, T.-H.; Liu, B.-Z.; Chen, K.; Zhang, D.; Li, T. Cross-Linking Methods of Type I Collagen-Based Scaffolds for Cartilage Tissue Engineering. Am. J. Transl. Res. 2022, 14, 1146–1159. [Google Scholar] [PubMed]
- Fan, Y.; Choi, T.-H.; Chung, J.-H.; Jeon, Y.-K.; Kim, S. Hyaluronic Acid-Cross-Linked Filler Stimulates Collagen Type 1 and Elastic Fiber Synthesis in Skin through the TGF-β/Smad Signaling Pathway in a Nude Mouse Model. J. Plast. Reconstr. Aesthetic Surg. 2019, 72, 1355–1362. [Google Scholar] [CrossRef] [PubMed]
- Buchbinder, L.; Baris, Y.; Alff, E.; Reynolds, E.; Dillon, E.; Pessin, V.; Pincus, L.; Strauss, A. Studies to Formulate New Media for the Standard Plate Count of Dairy Products. Public Health Rep. (Wash. D. C. 1896) 1951, 66, 327–340. [Google Scholar] [CrossRef]
- Panda, P.K.; Sadeghi, K.; Park, K.; Seo, J. Regeneration Approach to Enhance the Antimicrobial and Antioxidant Activities of Chitosan for Biomedical Applications. Polymers 2023, 15, 132. [Google Scholar] [CrossRef]
- Tran Vo, T.M.; Nakajima, K.; Potiyaraj, P.; Kobayashi, T. In Situ Sono-Rheometric Assessment of Procaine-Loaded Calcium Pectinate Hydrogel for Enhanced Drug Releasing under Ultrasound Stimulation. Int. J. Biol. Macromol. 2024, 262, 130164. [Google Scholar] [CrossRef]
- Liu, H.-W.; Hou, P.-P.; Guo, X.-Y.; Zhao, Z.-W.; Hu, B.; Li, X.; Wang, L.-Y.; Ding, J.-P.; Wang, S. Structural Basis for Calcium and Magnesium Regulation of a Large Conductance Calcium-Activated Potassium Channel with Β1 Subunits*. J. Biol. Chem. 2014, 289, 16914–16923. [Google Scholar] [CrossRef] [PubMed]
- Mu, Y.; Du, Z.; Xiao, L.; Gao, W.; Crawford, R.; Xiao, Y. The Localized Ionic Microenvironment in Bone Modelling/Remodelling: A Potential Guide for the Design of Biomaterials for Bone Tissue Engineering. J. Funct. Biomater. 2023, 14, 56. [Google Scholar] [CrossRef] [PubMed]
- Ballester-Beltrán, J.; Biggs, M.J.P.; Dalby, M.J.; Salmerón-Sánchez, M.; Leal-Egaña, A. Sensing the Difference: The Influence of Anisotropic Cues on Cell Behavior. Front. Mater. 2015, 2, 39. [Google Scholar] [CrossRef]
- Curtis, R.; Ulrich, J.; Montaser, A.; Prausnitz, J.; Blanch, H. Protein-Protein Interactions in Concentrated Electrolyte Solutions: Hofmeister-Series Effects. Biotechnol. Bioeng. 2002, 79, 367–380. [Google Scholar] [CrossRef] [PubMed]
- Rasidek, N.A.M.; Nordin, M.F.M.; Iwamoto, K.; Rahman, N.A.; Nagatsu, Y.; Tokuyama, H. Rheological Flow Models of Banana Peel Pectin Jellies as Affected by Sugar Concentration. Int. J. Food Prop. 2018, 21, 2087–2099. [Google Scholar] [CrossRef]
- Kazemi, M.; Khodaiyan, F.; Hosseini, S.S. Utilization of Food Processing Wastes of Eggplant as a High Potential Pectin Source and Characterization of Extracted Pectin. Food Chem. 2019, 294, 339–346. [Google Scholar] [CrossRef] [PubMed]
- Rwei, S.-P.; Chen, S.-W.; Mao, C.-F.; Fang, H.-W. Viscoelasticity and Wearability of Hyaluronate Solutions. Biochem. Eng. J. 2008, 40, 211–217. [Google Scholar] [CrossRef]
- Kobayashi, T.; Nagai, T.; Suzuki, T.; Nosaka, Y.; Fujii, N. Restricted Permeation of Dextransulfates by Electrostatic Barrier of Negatively Charged Ultrafiltration Membranes: Salt Effect on the Permeation. J. Memb. Sci. 1994, 86, 47–56. [Google Scholar] [CrossRef]
- Le, H.V.; Le Cerf, D. Colloidal Polyelectrolyte Complexes from Hyaluronic Acid: Preparation and Biomedical Applications. Small 2022, 18, 2204283. [Google Scholar] [CrossRef]
- Wang, M.D.; Zhai, P.; Schreyer, D.J.; Zheng, R.S.; Sun, X.D.; Cui, F.Z.; Chen, X.B. Novel Crosslinked Alginate/Hyaluronic Acid Hydrogels for Nerve Tissue Engineering. Front. Mater. Sci. 2013, 7, 269–284. [Google Scholar] [CrossRef]
- Bang, S.; Das, D.; Yu, J.; Noh, I. Evaluation of MC3T3 Cells Proliferation and Drug Release Study from Sodium Hyaluronate-1,4-Butanediol Diglycidyl Ether Patterned Gel. Nanomaterials 2017, 7, 328. [Google Scholar] [CrossRef] [PubMed]
- Musilová, L.; Mráček, A.; Kašpárková, V.; Minařík, A.; Valente, A.J.M.; Azevedo, E.F.G.; Veríssimo, L.M.P.; Rodrigo, M.M.; Esteso, M.A.; Ribeiro, A.C.F. Effect of Hofmeister Ions on Transport Properties of Aqueous Solutions of Sodium Hyaluronate. Int. J. Mol. Sci. 2021, 22, 1932. [Google Scholar] [CrossRef] [PubMed]
- Giubertoni, G.; Pérez de Alba Ortíz, A.; Bano, F.; Zhang, X.; Linhardt, R.J.; Green, D.E.; DeAngelis, P.L.; Koenderink, G.H.; Richter, R.P.; Ensing, B.; et al. Strong Reduction of the Chain Rigidity of Hyaluronan by Selective Binding of Ca2+ Ions. Macromolecules 2021, 54, 1137–1146. [Google Scholar] [CrossRef] [PubMed]
- Havlíková, M.; Jugl, A.; Kadlec, M.; Smilek, J.; Chang, C.-H.; Pekař, M.; Mravec, F. Catanionic Vesicles and Their Complexes with Hyaluronan—A Way How to Tailor Physicochemical Properties via Ionic Strength. J. Mol. Liq. 2023, 371, 121089. [Google Scholar] [CrossRef]
- Wójcik-Pastuszka, D.; Stawicka, K.; Dryś, A.; Musiał, W. Influence of HA on Release Process of Anionic and Cationic API Incorporated into Hydrophilic Gel. Int. J. Mol. Sci. 2023, 24, 5606. [Google Scholar] [CrossRef]
- Bravo, B.; Correia, P.; Gonçalves Junior, J.E.; Sant’Anna, B.; Kerob, D. Benefits of Topical Hyaluronic Acid for Skin Quality and Signs of Skin Aging: From Literature Review to Clinical Evidence. Dermatol. Ther. 2022, 35, e15903. [Google Scholar] [CrossRef]

| Cations | Conc. (mg/kg) | mval % * | Anions | Conc. (mg/kg) | mval % * |
|---|---|---|---|---|---|
| Li+ | 0.3 | 0.15 | F− | 4.8 | 0.91 |
| Na+ | 544.4 | 84.72 | Cl− | 648.8 | 65.99 |
| K+ | 7.1 | 0.65 | Br− | 2.3 | 0.10 |
| NH4+ | 0.7 | 0.14 | I− | 0.4 | 0.01 |
| Mg2+ | 2.5 | 0.74 | HS− | 7.2 | 0.79 |
| Ca2+ | 75.8 | 13.54 | S2O32− | 4.7 | 0.30 |
| Sr2+ | 0.7 | 0.06 | SO42− | 309.6 | 23.24 |
| - | - | - | HCO3− | 146.5 | 8.66 |
Disclaimer/Publisher’s Note: The statements, opinions and data contained in all publications are solely those of the individual author(s) and contributor(s) and not of MDPI and/or the editor(s). MDPI and/or the editor(s) disclaim responsibility for any injury to people or property resulting from any ideas, methods, instructions or products referred to in the content. |
© 2024 by the authors. Licensee MDPI, Basel, Switzerland. This article is an open access article distributed under the terms and conditions of the Creative Commons Attribution (CC BY) license (https://creativecommons.org/licenses/by/4.0/).
Share and Cite
Nakajima, K.; Tran Vo, T.M.; Adlin, N. Utilization of Multi-Ionic Interaction of Yumoto Hot Springs for Enhancing the Moisturizing Properties of Hyaluronic Acid Sodium Salt. Polysaccharides 2024, 5, 100-111. https://doi.org/10.3390/polysaccharides5020008
Nakajima K, Tran Vo TM, Adlin N. Utilization of Multi-Ionic Interaction of Yumoto Hot Springs for Enhancing the Moisturizing Properties of Hyaluronic Acid Sodium Salt. Polysaccharides. 2024; 5(2):100-111. https://doi.org/10.3390/polysaccharides5020008
Chicago/Turabian StyleNakajima, Keita, Tu Minh Tran Vo, and Nur Adlin. 2024. "Utilization of Multi-Ionic Interaction of Yumoto Hot Springs for Enhancing the Moisturizing Properties of Hyaluronic Acid Sodium Salt" Polysaccharides 5, no. 2: 100-111. https://doi.org/10.3390/polysaccharides5020008
APA StyleNakajima, K., Tran Vo, T. M., & Adlin, N. (2024). Utilization of Multi-Ionic Interaction of Yumoto Hot Springs for Enhancing the Moisturizing Properties of Hyaluronic Acid Sodium Salt. Polysaccharides, 5(2), 100-111. https://doi.org/10.3390/polysaccharides5020008





